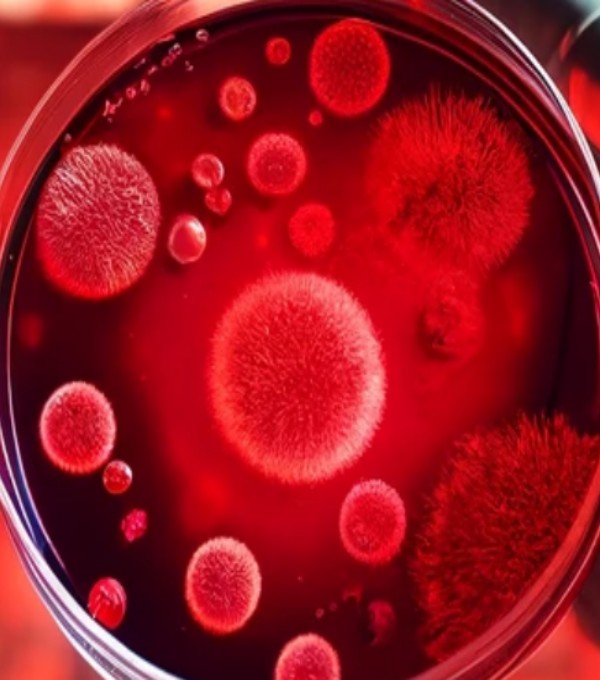
https://bioenergyanalytics.ca/wp-content/uploads/2024/04/Focused-Red-Petri-Dish.jpg

Metabolic research: unlocking health worldwide.
Our innovative metabolic research lays the groundwork for proactive disease prevention. By targeting key metabolic pathways, we’re shaping future strategies to intercept disease progression early, offering promising avenues for prevention and management.
From meticulously planning every step of the research process to employing rigorous quality control measures, we leave no stone unturned in our pursuit of excellence.
BIOENERGY ANALYTICS IN NUMBERS
YEARS OF EXPERIENCE
RESEARCH OUTPUTS
COLLABORATION AND PARTNERSHIPS
We are dedicated to:
COLLABORATION
ETHICAL CONDUCT
TRANSLATION AND APPLICATION
PATIENT-CENTRICITY
SCIENTIFIC RIGOR
INNOVATION